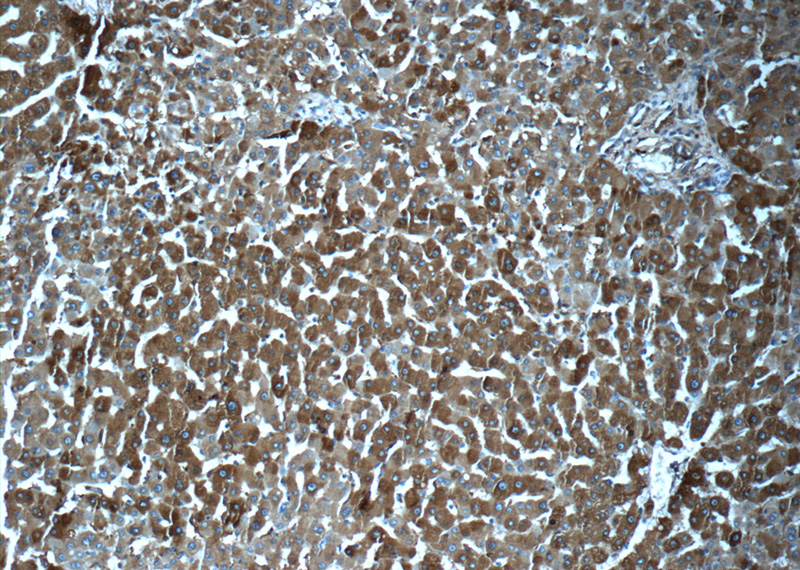
Immunohistochemistry of paraffin-embedded human liver tissue slide using Catalog No:110622(FTL Antibody) at dilution of 1:50 (under 10x lens)
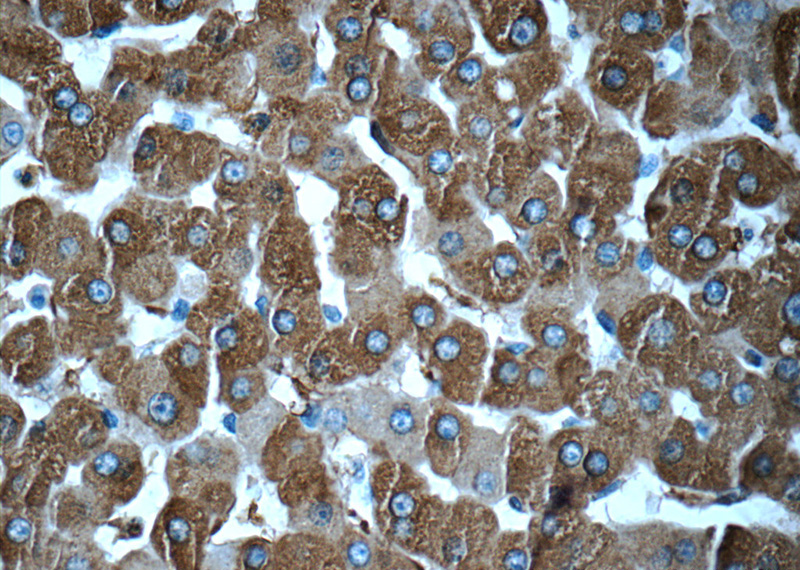
Immunohistochemistry of paraffin-embedded human liver tissue slide using Catalog No:110622(FTL Antibody) at dilution of 1:50 (under 40x lens)

-
Product Name
Ferritin light chain antibody
- Documents
-
Description
Ferritin light chain Rabbit Polyclonal antibody. Positive IHC detected in human liver tissue, human liver cancer tissue, human spleen tissue. Positive IF detected in HepG2 cells. Positive IP detected in mouse liver tissue. Positive WB detected in human placenta tissue, mouse brain tissue, mouse liver tissue, mouse ovary tissue, mouse spleen tissue. Observed molecular weight by Western-blot: 20-22 kDa
-
Tested applications
ELISA, WB, IP, IHC, IF
-
Species reactivity
Human,Mouse,Rat; other species not tested.
-
Alternative names
Ferritin L subunit antibody; Ferritin light chain antibody; ferritin antibody; light polypeptide antibody; FTL antibody
-
Isotype
Rabbit IgG
-
Preparation
This antibody was obtained by immunization of Ferritin light chain recombinant protein (Accession Number: NM_000146). Purification method: Antigen affinity purified.
-
Clonality
Polyclonal
-
Formulation
PBS with 0.1% sodium azide and 50% glycerol pH 7.3.
-
Storage instructions
Store at -20℃. DO NOT ALIQUOT
-
Applications
Recommended Dilution:
WB: 1:500-1:5000
IP: 1:500-1:5000
IHC: 1:20-1:200
IF: 1:10-1:100
-
Validations

human placenta tissue were subjected to SDS PAGE followed by western blot with Catalog No:110622(FTL antibody) at dilution of 1:1000

IP Result of anti-FTL (IP:Catalog No:110622, 3ug; Detection:Catalog No:110622 1:1000) with mouse liver tissue lysate 12500ug.
Immunohistochemistry of paraffin-embedded human liver tissue slide using Catalog No:110622(FTL Antibody) at dilution of 1:50 (under 10x lens)
Immunohistochemistry of paraffin-embedded human liver tissue slide using Catalog No:110622(FTL Antibody) at dilution of 1:50 (under 40x lens)

Immunofluorescent analysis of HepG2 cells using Catalog No:110622(FTL Antibody) at dilution of 1:25 and Alexa Fluor 488-congugated AffiniPure Goat Anti-Rabbit IgG(H+L)
-
Background
FTL belongs to the ferritin family. It stores iron in a soluble, non-toxic, readily available form. FTL is important for iron homeostasis. It plays a role in delivery of iron to cells. FTL mediates iron uptake in capsule cells of the developing kidney. Mutation of FTL will cause hereditary hyperferritinemia-cataract syndrome (HHCS) or neurodegeneration with brain iron accumulation type 3 (NBIA3). Ferritin light polypeptide (FTL) and ferritin heavy polypeptide (FTH1) were the main constituents the striatum and cerebellar cortex revealed.
-
References
- Dowdle WE, Nyfeler B, Nagel J. Selective VPS34 inhibitor blocks autophagy and uncovers a role for NCOA4 in ferritin degradation and iron homeostasis in vivo. Nature cell biology. 16(11):1069-79. 2014.
- Xu YX, Du F, Jiang LR. Effects of aspirin on expression of iron transport and storage proteins in BV-2 microglial cells. Neurochemistry international. 91:72-7. 2015.
- Bagnato F, Hametner S, Yao B. Tracking iron in multiple sclerosis: a combined imaging and histopathological study at 7 Tesla. Brain : a journal of neurology. 134(Pt 12):3602-15. 2011.
- Hametner S, Wimmer I, Haider L, Pfeifenbring S, Brück W, Lassmann H. Iron and neurodegeneration in the multiple sclerosis brain. Annals of neurology. 74(6):848-61. 2013.
- Chen RX, Song HY, Dong YY. Dynamic expression patterns of differential proteins during early invasion of hepatocellular carcinoma. PloS one. 9(3):e88543. 2014.
Related Products / Services
Please note: All products are "FOR RESEARCH USE ONLY AND ARE NOT INTENDED FOR DIAGNOSTIC OR THERAPEUTIC USE"
